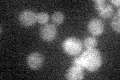
YNL101W

View description
Vacuolar transporter, exports large neutral amino acids from the vacuole; member of a family of seven S. cerevisiae genes (AVT1-7) related to vesicular GABA-glycine transporters
Localization:
Intensity:
Fold change:
Significance:
-
C’ GFP library in SD
below threshold21.18 -
N' NOP1pr-GFP in SD

N/A0 -
N' TEF2pr-mCherry in SD

N/A0 -
N' NATIVEpr-GFP in SD

N/A0 -
N' TEF2pr-VC and Cyto-VN in SD

N/A0 -
C’ GFP library in SD+DTT

cytosol18.020.85No -
C’ GFP library in SD+H2O2

cytosol19.80.93No -
C’ GFP library in Starvation Media

cytosol19.610.92No -
C’ GFP library on the background of Pup2-DaMP

below threshold -
C’ GFP library on the background of CCT mutant

below threshold16.31440.769922No
